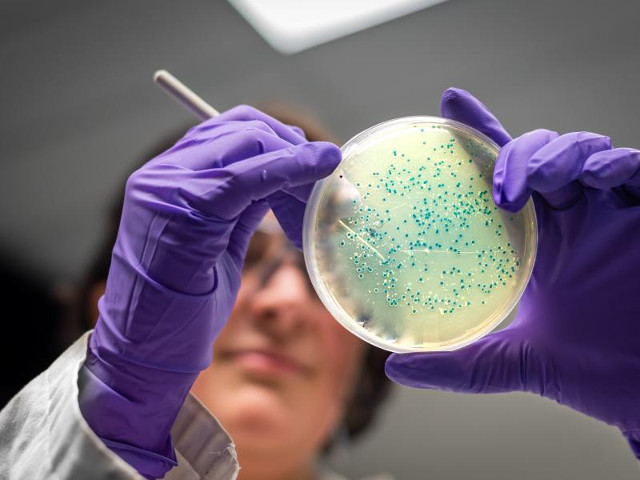
A moment of the lab work on Escherichia coli (Photo courtesy Rensselaer Polytechnic Institute. All rights reserved)

Tiamat’s Wrath by James S.A. Corey
The novel “Tiamat’s Wrath” by James S.A. Corey was published for the first time in 2019. It’s the eighth book in the Expanse series and follows “Persepolis Rising”.
Laconia has quickly become the ruler of humanity thanks to the technologies developed by studying the protomolecule. Despite this, the High Consul Duarte knows that his ambitions could clash with the alien species that annihilated the creators of the protomolecule. He has enlisted Dr. Elvi Okoye to study any trace of this alien species, and at the same time prepares for the worst by training his daughter Teresa to succeed him even if she’s only 14 years old.
Naomi Nagata continues her work with the resistance movement in the solar system. With James Holden captive on Laconia and Amos missing in action, she is left with Alex and Bobbie, but fighting Laconia seems like a mission impossible, at least until an attack on a Laconian spaceship that appears to have ended in half failure reveals unexpected results.